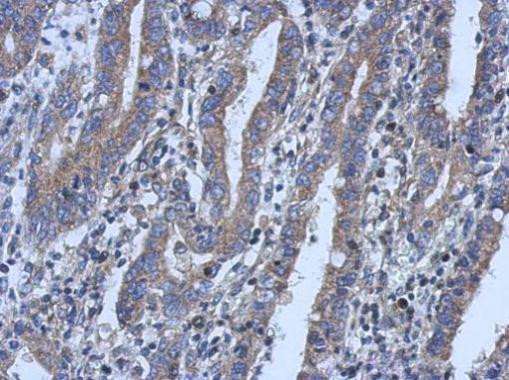
LYPLA3 Antibody in Immunohistochemistry (Paraffin) (IHC (P))

Search
Invitrogen
LYPLA3 Polyclonal Antibody
{{$productOrderCtrl.translations['antibody.pdp.commerceCard.promotion.promotions']}}
{{$productOrderCtrl.translations['antibody.pdp.commerceCard.promotion.viewpromo']}}
{{$productOrderCtrl.translations['antibody.pdp.commerceCard.promotion.promocode']}}: {{promo.promoCode}} {{promo.promoTitle}} {{promo.promoDescription}}. {{$productOrderCtrl.translations['antibody.pdp.commerceCard.promotion.learnmore']}}
产品信息
PA5-31700
宿主/亚型
分类
类型
抗原
偶联物
形式
浓度
规格
保存条件
运输条件
RRID
产品详细信息
Recommended positive controls: HepG2.
Predicted reactivity: Mouse (88%), Rat (87%), Dog (89%), Rhesus Monkey (97%).
Store product as a concentrated solution. Centrifuge briefly prior to opening the vial.
靶标信息
Lysophospholipases are enzymes that act on biological membranes to regulate the multifunctional lysophospholipids. The protein encoded by this gene hydrolyzes lysophosphatidylcholine to glycerophosphorylcholine and a free fatty acid. This enzyme is present in the plasma and thought to be associated with high-density lipoprotein. A later paper contradicts the function of this gene. It demonstrates that this gene encodes a lysosomal enzyme instead of a lysophospholipase and has both calcium-independent phospholipase A2 and transacylase activities.
⚠WARNING: This product can expose you to chemicals including mercury, which is known to the State of California to cause birth defects or other reproductive harm. For more information go to www.P65Warnings.ca.gov.
仅用于科研。不用于诊断过程。未经明确授权不得转售。